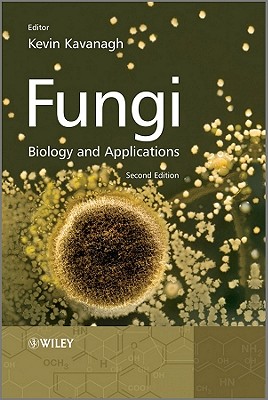
Fungi: Biology and Applications

Store-PhatpocketLimited Visit
Sort by

Bisley, Geoffrey G
A Handbook of Ophthalmology for Developing Countries (Oxford Medical Publications)
$245.17




European Commission Enterprise DG
Responsible Entrepreneurship: a Collection of Good Practice Cases Among Small and Medium-Sized Enterprises Across Europe
$88.95

Default Sort attempts to select a random list for the listing of items.







